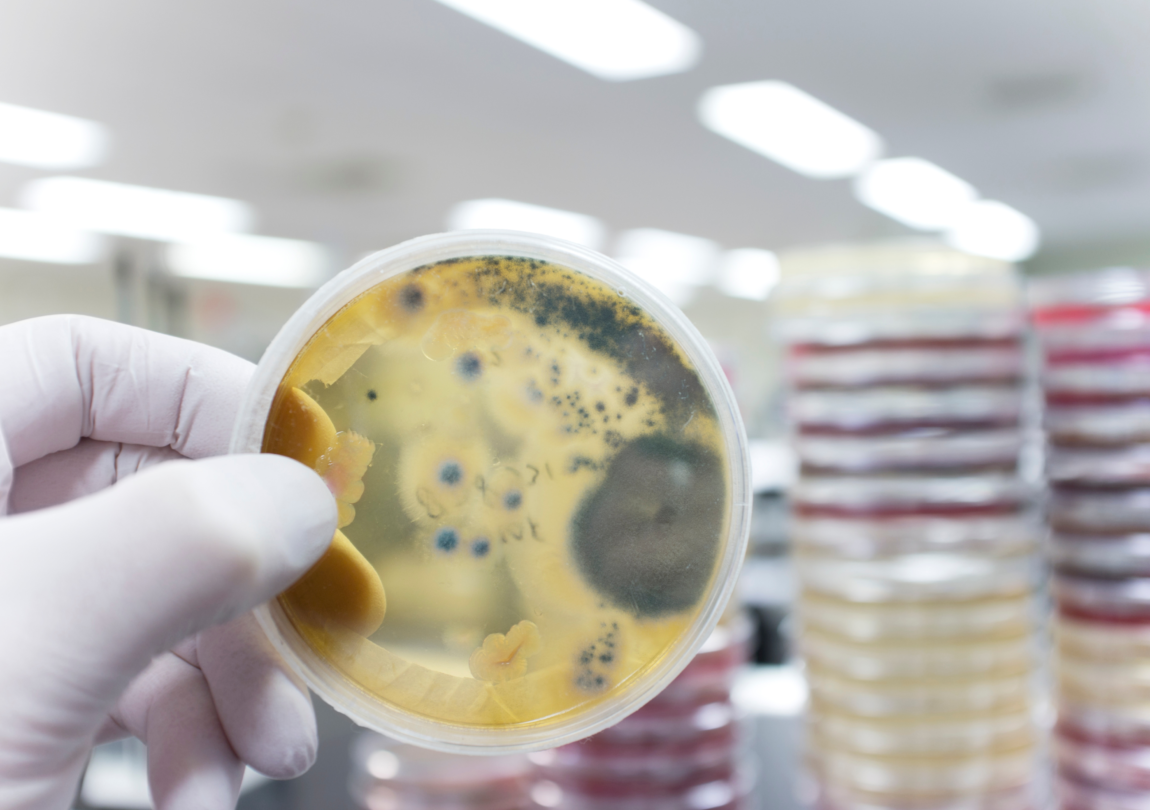
bahaya air keruh

Cara Menerapkan Diet Intermitten Fasting Bagi Pemula
Diet Intermitten Fasting semakin populer karena sederhana, fleksibel, dan memberikan banyak manfaat kesehatan. Metode ini tidak hanya membantu menurun ...

Diet Intermitten Fasting semakin populer karena sederhana, fleksibel, dan memberikan banyak manfaat kesehatan. Metode ini tidak hanya membantu menurun ...

Apakah resolusi tahun barumu memiliki tubuh ideal dan hendak menjalankan program diet? Jika iya, kamu harus mengetahui berbagai jenis diet sebelum mem ...

Berat badan yang berlebih dan tidak seimbang, membuat sebagian orang merasa kurang percaya diri. Di samping itu, memiliki berat badan berlebih juga me ...

Musim hujan membawa hawa dingin yang sering membuat kita merasa ingin buang air kecil lebih sering dari biasanya. Saat tubuh beradaptasi dengan cuaca ...

Berasal dari mana sumber air minum di rumahmu? Air dalam kemasan atau air keran yang direbus? Lalu, di antara keduanya manakah yang lebih dianjurkan u ...

Memasuki bulan November hujan sudah terjadi pada sejumlah titik di Indonesia. Membuat perubahan cuaca drastis yang mengakibatkan tubuh rentan terhadap ...

Saat cuaca dingin, banyak orang cenderung mengabaikan kebutuhan cairan tubuh mereka. Padahal, menjaga hidrasi tubuh sama pentingnya di cuaca dingin se ...

Puncak musim hujan di Indonesia diperkirakan terjadi di bulan November dan Desember tahun 2024, juga Januari – Februari tahun 2025. Meskipun mus ...

Berbicara mengenai musim hujan, memang kerap membawa tantangan tersendiri terkait kebersihan maupun kesehatan. Salah satu aspek penting yang harus kit ...
Hujan merupakan suatu fenomena alam yang menjadi berkah bagi alam semesta. Akan tetapi, hujan yang terus – menerus terkadang juga menimbulkan be ...